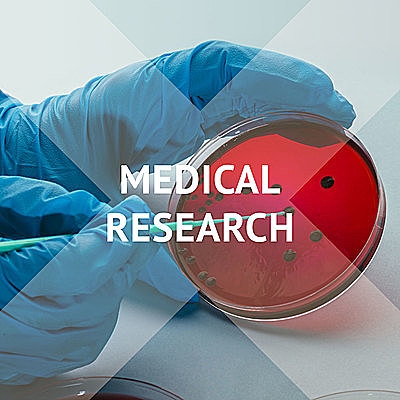
Medical Research

Poslední nově vydaná alba.
Všechna albaVe zpravodajství
digitalizace stavebního řízení
Fantastická Muchová
Evropa očekává další silné přívalové deště
Irán zaútočil na Izrael
Česko zaplavila 100 letá voda
Biden odstoupil z prezidentských voleb
Záložna, kde měl Fiala milion, čelila vyšetřování FAÚ i ČNB. I kvůli praní peněz
Australian Open
Rallye Paříž Dakar
Vánoce
01 | Evripides Evripidou | STŘEDNÍ | 01:35 | |
02 | Jon Hansson | STŘEDNÍ | 02:16 | |
03 | Moritz Bintig | STŘEDNÍ | 01:53 | |
04 | Patrick Puszko, Stephan Schelens | STŘEDNÍ | 02:20 | |
05 | Louis Edlinger | STŘEDNÍ | 02:17 |
Playlisty vytvořené předními hudebními kurátory
Všechny playlistyPřinášíme nový label ICONICA
Využívají naši hudbu







.png&w=640&q=100)






.png&w=640&q=100)
.png&w=640&q=100)






.png&w=640&q=100)













.png&w=640&q=100)

















.png&w=640&q=100)
.png&w=640&q=100)